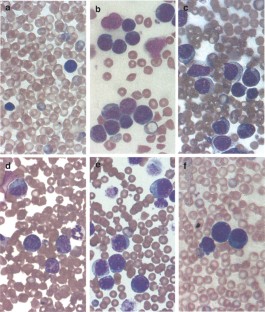

Abstract
To analyse individual factors that may contribute to leukemic transformation in vivo, we have developed a murine model of leukemogenesis based on the early hematopoietic precursor cell FL5.12. FL5.12 cells are interleukin-3 (IL-3) dependent for growth, proliferation, and survival. Relative resistance to cell death following IL-3 withdrawal can be conferred by either overexpression of the Bcl-xL apoptotic inhibitor, or constitutive activation of the serine/threonine kinase Akt. The ability of Bcl-xL or a constitutively active myristylated Akt to promote leukemic transformation of FL5.12 cells was compared in athymic nu+/nu+ mice. Bcl-xL alone could not promote leukemic transformation, but mice injected with FL5.12 cells overexpressing Bcl-xL and a dominant-negative p53 construct developed leukocytosis and blastic infiltration of lymph nodes, spleen, and liver with features of a high-grade lymphoid malignancy. In contrast to the cells injected into these animals, cell lines derived from the mice were able to proliferate in the absence of IL-3, and were found to have constitutively activated Akt. This constitutive activation was associated with a variety of alterations of the signaling pathway regulating Akt activity, including alterations of PTEN mRNA and protein expression. In addition, some of these leukemic clones demonstrated concurrent constitutive upregulation of ERK activity. A constitutively active Akt construct introduced into FL5.12 cells promoted similar clonal expansion in vivo, with emergence of clonal IL-3-independent proliferation. Bcl-xL and Akt appeared to function cooperatively in this model, enhancing rapid clonal outgrowth in vivo relative to Akt alone. These results implicate activated Akt and growth-factor independence in leukemogenic transformation, and demonstrate the potential for in vivo analysis of genetic determinants of leukemogenesis.
This is a preview of subscription content, access via your institution
Access options
Subscribe to this journal
Receive 50 print issues and online access
$259.00 per year
only $5.18 per issue
Buy this article
- Purchase on SpringerLink
- Instant access to the full article PDF.
USD 39.95
Prices may be subject to local taxes which are calculated during checkout

Similar content being viewed by others
References
Adams JM and Cory S . (2001). Trends Biochem. Sci., 26, 61–66.
Barlow C, Eckhaus MA, Schaffer AA and Wynshaw-Boris A . (1999). Nat. Genet., 21, 359–360.
Barthel A, Okino ST, Liao J, Nakatani K, Li J, Whitlock Jr JP and Roth RA . (1999). J Biol. Chem., 274, 20281–20286.
Bellacosa A, Franke TF, Gonzalez-Portal ME, Datta K, Taguchi T, Gardner J, Cheng JQ, Testa JR and Tsichlis PN . (1993). Oncogene, 8, 745–754.
Boise LH, Gonzalez-Garcia M, Postema CE, Ding L, Lindsten T, Turka LA, Mao X, Nunez G and Thompson CB . (1993). Cell, 74, 597–608.
Cheng JQ, Ruggeri B, Klein WM, Sonoda G, Altomare DA, Watson DK and Testa JR . (1996). Proc. Natl. Acad. Sci. USA, 93, 3636–3641.
Cross DA, Watt PW, Shaw M, van der Kaay J, Downes CP, Holder JC and Cohen P . (1997). FEBS Lett, 406, 211–215.
Datta SR, Brunet A and Greenberg ME . (1999). Genes Dev., 13, 2905–2927.
Della Ragione F, Mercurio C and Iolascon A . (1995). Haematologica, 80, 557–568.
Downward J . (1998). Curr. Opin. Genet. Dev., 8, 49–54.
Drexler HG, MacLeod RA, Borkhardt A and Janssen JW . (1995). Leukemia, 9, 480–500.
Gottlob K, Majewski N, Kennedy S, Kandel E, Robey RB and Hay N . (2001). Genes Dev., 15, 1406–1418.
Huang Z . (2000). Oncogene, 19, 6627–6631.
Issa JP, Baylin SB and Herman JG . (1997). Leukemia, 11(Suppl. 1), S7–S11.
Klein G . (2000). BioEssays, 22, 414–422.
Komuro H, Valentine MB, Rubnitz JE, Saito M, Raimondi SC, Carroll AJ, Yi T, Sherr CJ and Look AT . (1999). Neoplasia, 1, 253–261.
Korsmeyer SJ . (1992). Annu. Rev. Immunol., 10, 785–807.
Lawlor MA and Alessi DR . (2001). J. Cell Sci., 114, 2903–2910.
Lund AH, Turner G, Trubetskoy A, Verhoeven E, Wientjens E, Hulsman D, Russell R, DePinho RA, Lenz J and van Lohuizen M . (2002). Nat. Genet., 32, 160–165.
McKeam JP, McCubrey J and Fagg B . (1985). Proc. Natl. Acad. Sci. USA, 82, 7414–7418.
Minn AJ, Boise LH and Thompson CB . (1996). Genes Dev., 10, 2621–2631.
Minn AJ, Kettlun CS, Liang H, Kelekar A, Vander Heiden MG, Chang BS, Fesik SW, Fill M and Thompson CB . (1999). EMBO J., 18, 632–643.
Nicholson KM and Anderson NG . (2002). Cell Signal., 14, 381–395.
Plas DR, Talapatra S, Edinger AL, Rathmell JC and Thompson CB . (2001). J. Biol. Chem., 276, 12041–12048.
Plas DR and Thompson CB . (2002). Trends Endocrinol. Metab., 13, 75–78.
Rowley JD . (2000). Semin. Hematol., 37, 315–319.
Rudin CM and Thompson CB . (2001). Metabolic and Molecular Bases of Inherited Diseases, 8th edn. Scriver CR, Beaudet AL, Sly SW and Valle D (eds). McGraw-Hill: New York, pp. 631–644.
Song WJ, Sullivan MG, Legare RD, Hutchings S, Tan X, Kufrin D, Ratajczak J, Resende IC, Haworth C, Hock R, Loh M, Felix C, Roy DC, Busque L, Kurnit D, Willman C, Gewirtz AM, Speck NA, Bushweller JH, Li FP, Gardiner K, Poncz M, Maris JM and Gilliland DG . (1999). Nat. Genet. 23, 166–175.
Shaulian E, Zauberman A, Ginzberg D and Oren M . (1992). Mol. Cell. Biol., 12, 5581–5592.
Staal SP (1987). Proc Natl. Acad. Sci. USA, 84, 5034–5037.
Talapatra S and Thompson CB . (2001). J. Pharmacol. Exp. Ther., 298, 873–878.
Vander Heiden MG, Chandel NS, Williamson EK, Schumacker PT and Thompson CB . (1997). Cell, 91, 627–637.
Vander Heiden MG, Plas DR, Rathmell JR, Fox CJ, Harris MH and Thompson CB . (2001). Mol. Cell. Biol., 21, 5899–5912.
Vander Heiden MG and Thompson CB . (1999). Nat. Cell. Biol., 1, E209–E216.
Veldman T, Vignon C, Schrock E, Rowley JD and Ried T . (1997). Nat. Genet., 15, 406–410.
Weissman IL, Anderson DJ and Gage F . (2001). Annu. Rev. Cell Dev. Biol., 17, 387–403.
Xerri L, Hassoun J, Devilard E, Birnbaum D and Birg F . (1998). Leuk. Lymphoma, 28, 451–458.
Acknowledgements
We thank Michelle Le Beau for several helpful discussions regarding this project and manuscript, and Theodore Karrison for statistical analysis. This work was supported by NIH CA81138 (CMR).
Author information
Authors and Affiliations
Corresponding author
Rights and permissions
About this article
Cite this article
Karnauskas, R., Niu, Q., Talapatra, S. et al. Bcl-xL and Akt cooperate to promote leukemogenesis in vivo. Oncogene 22, 688–698 (2003). https://doi.org/10.1038/sj.onc.1206159
Received:
Revised:
Accepted:
Published:
Issue date:
DOI: https://doi.org/10.1038/sj.onc.1206159
Keywords
This article is cited by
-
SIRT2 activates G6PD to enhance NADPH production and promote leukaemia cell proliferation
Scientific Reports (2016)
-
Glycolysis inhibition for anticancer treatment
Oncogene (2006)
-
A moderate reduction of Bcl-xL expression protects against tumorigenesis; however, it also increases susceptibility to tissue injury
Oncogene (2005)
-
ATP citrate lyase is an important component of cell growth and transformation
Oncogene (2005)
-
Chronic myeloid leukaemia: an investigation into the role of Bcr-Abl-induced abnormalities in glucose transport regulation
Oncogene (2005)


